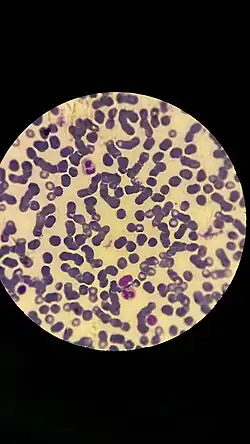

Linfocito
| Linfocito | ||
|---|---|---|
![]() Representación 3D de un linfocito B. | ||
![]() Representación 3D de un linfocito T. | ||
| Nombre y clasificación | ||
| Latín | Lymphocytus | |
| TH | H2.00.04.1.02002 | |
| TH | H2.00.04.1.02002 | |
| Información anatómica | ||
| Región | sistema linfático | |
|
| ||


Los linfocitos son células del sistema inmunitario. Son un tipo de leucocito que provienen de la diferenciación linfoide de las células madre hematopoyéticas ubicadas en la médula ósea y que completan su desarrollo en los órganos linfoides primarios y secundarios (médula ósea, timo, bazo, ganglios linfáticos y tejidos linfoides asociados a las mucosas). Los linfocitos circulan por todo el organismo a través del aparato circulatorio y el sistema linfático.[1][2]
Son los leucocitos de menor tamaño (entre 9 y 18 μm), y representan aproximadamente el 30 % (del 20 a 40 %) del total en la sangre periférica. Su morfología es variable, de acuerdo con la cual se clasifican en linfoblastos, prolinfocitos y linfocitos propiamente tal, ya sea inactivos o activados (como los plasmocitos). Presentan un gran núcleo esférico que se tiñe de violeta-azul y la cantidad de citoplasma varía entre escaso (situación más frecuente, en la cual el citoplasma se observa como un anillo periférico de color azul) a abundante. En el citoplasma se encuentran algunas mitocondrias, ribosomas libres y un pequeño aparato de Golgi.[2]
La función principal de los linfocitos es la regulación de la respuesta inmunitaria adaptativa (o específica), reaccionando frente a materiales extraños (microorganismos, células tumorales o antígenos en general). Para ello se diferencian en tres líneas de células reactivas: los linfocitos T que se desarrollan en el timo y que participan en la respuesta inmunitaria celular; los linfocitos B, que se desarrollan en la médula ósea y luego migran a diferentes tejidos linfáticos, que son las encargadas de la respuesta inmunitaria humoral, transformándose en plasmocitos que producen anticuerpos; y las células NK (natural killer) que destruyen células infectadas. Los linfocitos T y B presentan receptores específicos, las asesinas naturales (NK) no.[2][3]
Estas células se localizan fundamentalmente en la linfa y los órganos linfoides y en la sangre. Tienen receptores para antígenos específicos y, por tanto, pueden encargarse de la producción de anticuerpos y de la destrucción de células anormales. Estas respuestas ocurren en el interior de los órganos linfoides, los cuales, para tal propósito, deben suministrar un entorno que permita la interacción eficiente entre linfocitos, macrófagos y antígeno extraño.
Tipos

1. Proteína invasora/antígeno
2. Macrófago/Célula presentadora de antígeno
3. Complejo antígeno:MHC II (presentación de antígeno), activación de linfocito Th
4. Linfocito Th (cooperador)
5. Proteína invasora unido a anticuerpos de membrana
6. Linfocito B
7. Procesamiento de antígeno (MHC tipo II)
8. Complejo antígeno:MHC II (presentación de antígeno)
9. Producción de anticuerpos específicos para el antígeno
10. Activación de linfocitos B con los Th activados.
La tipología de los linfocitos es difícil de catalogar según su morfología, por lo que se ocupan propiedades tales como la reactividad a anticuerpos monoclonales que identifican sus "CD" o cúmulos de diferenciación (del inglés cluster of differentiation), los cuales son un conjunto de marcadores biológicos para la identificación celular; el estado de reconfiguración de los genes de cadena pesada y cadena ligera de inmunoglobulina o receptores de linfocitos T y B; y la expresión de inmunoglobulinas en la superficie.[1]
Linfocitos B
Los linfocitos B maduran en dos etapas: la primera, sin mediar antígenos, que ocurre en la médula ósea y otra dependiente de la exposición a antígenos que ocurre en los órganos linfáticos secundarios (ganglios linfáticos, bazo y tejidos linfoides asociados a las mucosas) donde se transforman en células productoras y secretoras de anticuerpos. Los distintos tipos de linfocitos B en estas etapas son:[3][4]
- Estadio pro-B.
- Estadio pre-B.
- Linfocitos B inmaduros.
- Linfocitos B maduros.
Los linfocitos son los responsables de la respuesta humoral, transformándose en plasmocitos que producen glucoproteínas denominadas anticuerpos o inmunoglobulinas (Ig), las cuales se adhieren a un antígeno específico (al cual reconocen de manera unívoca). Todos los anticuerpos producidos por un linfocito B son específicos para un solo antígeno, por eso dichos anticuerpos se denominan monoclonales. También los linfocitos B interactúan con los linfocitos T con lo que proliferan y cambian el isotipo de inmunoglobulina (IgM, IgE, IgG, IgD, IgA ) que secretan, manteniendo la especificidad del antígeno. También los linfocitos B pueden actuar como células presentadoras de antígenos.[3]
Linfocitos T
Linfocitos T (timodependientes, ya que se diferencian en el timo): Detectan antígenos proteicos asociados a moléculas del complejo mayor de histocompatibilidad (MHC o CMH)
- Linfocitos T colaboradores (en inglés "helper") o linfocitos CD4+. Reconocen péptidos antigénicos presentados por el MHC-II en células dendríticas, linfocitos B, macrófagos y otras células presentadoras de antígenos. Se les denomina colaboradores porque están involucrados en la activación y dirección de otras células inmunitarias.[3]
- Linfocitos T citotóxicos o linfocitos CD8+. Reconocen péptidos presentados por MHC-I y tienen capacidad lítica.
- Linfocitos T reguladores o supresores que inhiben la producción de interleucinas de los linfocitos T colaboradores y por lo tanto detienen la respuesta inmunitaria específica.
- Linfocitos T de memoria que tras el primer contacto con un antígeno permanecen como células de memoria muchos años y que si se produjera un segundo contacto producirían linfocitos T citotóxicos y colaboradores rápidamente.
Linfocitos NK
- Célula asesina natural, Natural Killer o linfocito grande granular: juegan un papel muy similar al de los linfocitos T citotóxicos en la respuesta autoinmune adaptativa de nuestro organismo. Una célula NK actuará de manera inmediata ante la presencia de un antígeno, mientras que un linfocito T citotóxico necesitará de la respuesta inmune para activarse. Un Natural killer no necesita que los anticuerpos marquen a las células afectadas por el antígeno, sino que será capaz de reconocerlos inmediatamente para destruirlas.
Las células NK luchan contra el antígeno presente en la célula infectada o cancerígena de manera inmediata; mientras tanto la respuesta inmune adaptativa está generando células T citotóxicas específicas, para acabar con esas células en un segundo paso.
Tráfico de linfocitos
El tráfico de linfocitos entre los tejidos, el torrente sanguíneo y los ganglios linfáticos, permite que las células sensibles a los antígenos los busquen y sean reclutadas en sitios en los cuales se está desarrollando una respuesta. A su vez hay una diseminación de las células de memoria que permite la organización de una respuesta más amplia.
- Después de las 24 primeras horas (en que el antígeno se localiza por primera vez en los ganglios linfáticos o en el bazo) las células reactivas al antígeno sufren una depleción (disminución) del conjunto de linfocitos circundantes.
- Días más tarde (después de la proliferación del antígeno en el sitio de localización), en el conducto torácico aparece un pico de células activadas.
- En los linfáticos eferentes va a haber una caída en la producción de células, fenómeno designado como “cierre celular” o “atrapamiento de linfocitos” que se cree es el resultado de la liberación de factores solubles desde las células T inducida por el antígeno, este evento a estar seguido de una producción de blastos activados que alcanza un máximo a las 80 horas.
- Los linfocitos vírgenes ingresan al ganglio linfático a través de los linfáticos aferentes y por el pasaje guiado a través del endotelio de pared alta de las vénulas poscapilares especializado.
- Endotelios de este tipo posibilitan el tránsito de células vinculadas en la inmunidad de las mucosas a las placas de Peyer; también involucran la migración de linfocitos en tejidos normales e inflamados.
- Los linfocitos se unen a endotelios planos no especializados y los atraviesan.
- Los linfoblastos y las poblaciones de células de memoria muestran una migración limitada al tejido hacia los tejidos extralinfoides, como la piel o el epitelio mucoso; mientras que los linfocitos, neutrófilos y monolitos se dirigen y migran a sitios de inflamación en respuesta a mediadores producidos en forma local.
- Tráfico y recirculación de linfocitos a través del tejido linfoide encapsulado y los sitios de inflamación: Los linfocitos transportados por sangre entran en los tejidos y ganglios linfáticos atravesando el endotelio de paredes altas de las vénulas poscapilares (HEV) y salen a través de los linfáticos de drenaje. Los linfáticos eferentes, que salen desde el último ganglio se unen para formar el conducto torácico por el que retornan los linfocitos por vía sanguínea. En el bazo, que carece de HEV, los linfocitos ingresan en el área linfoide (pulpa blanca) desde las arteriolas y pasan hacia los sinusoides del área eritroide (pulpa roja) y salen por vía esplénica.
- Tráfico y circulación de linfocitos dentro del sistema linfoide asociado a mucosas-no encapsulado (MALT): Las células estimuladas por un antígeno se mueven desde las placas de Peyer, se mueven para colonizar la lámina propia y otras mucosas, y forman un sistema inmune de mucosas común.
- Este tráfico organizado se lleva a cabo dirigiendo los linfocitos relevantes a diferentes partes del sistema linfoide y a otros tejidos, mediante una serie de receptores guía que incluyen: miembros de la superfamilia de las integrinas (LFA-1, VLA, etc.) y un miembro de la suúperfamilia de las selectinas, que es la L-selectina.
Las integrinas pueden unirse a la matriz extracelular, a las proteínas plasmáticas y a otras moléculas de la superficie celular, sus ligandos complementarios incluyen las adresinas vasculares de superficie, presentes en el endotelio de los vasos sanguíneos.
Estos receptores guía actúan como puertas selectivas que permiten que las poblaciones particulares de linfocitos tengan acceso al tejido apropiado.
Las quimiocinas como SLC (quimiocina del tejido linfoide secundario) presentadas por el endotelio vascular, tienen un papel importante para la detección de linfocitos; los receptores de la integrinas están involucrados en la regulación positiva funcional de las integrinas.
Transmigración
- Paso N.º 1 - Adherencia y rotación: Para que el linfocito se adhiera a la célula endotelial, debe superar las fuerzas de cizallamiento creadas por el flujo sanguíneo. Esto se logra por medio de una fuerza de atracción entre los receptores guía (integrinas y L-selectina) y sus ligandos sobre la pared del vaso que opera a través de microvellosidades sobre la superficie del linfocito. Después de este proceso de adherencia; el linfocito rota a lo largo de la célula endotelial y las integrinas VLA-4 o LPAM-1 sobre el linfocito, se unen a sus ligandos sobre el endotelio.
- Paso N.º 2 - Activación de LFA-1 y aplanamiento: Este proceso conduce a la activación y el reclutamiento de la integrina LFA-1 hacia la superficie no vellosa del linfocito. Esta integrina se une con mucha fuerza a ICAM-1 e ICAM-2 sobre la célula endotelial, y el contacto íntimo hace que el linfocito se aplane.
- Paso N.º 3 - Diapédesis: El linfocito aplanado utiliza ahora la interacción LFA-1-ICAM y el miembro de la superfamilia de inmunoglobulinas PECAM-1 (molécula de adhesión al endotelio plaquetario, CD31, no solo presente en las plaquetas), para abrirse paso entre las células endoteliales y en el tejido, en respuesta a una señal quimiotáctica.
Patología
Linfocitosis
La proporción normal de linfocitos dentro de todos leucocitos varía entre 20 y 40%, y por lo tanto, una proporción que supere el 40%, determinaría una linfocitosis relativa.
Linfocitopenia
Se utiliza linfocitopenia para hacer referencia a un nivel anormalmente bajo de linfocitos en la sangre.
Véase también
- Célula dendrítica
- Glóbulo blanco
- Linfoadenopatía
- Linfocito B
- Linfocito grande granular
- Linfocito Natural Killer
- Linfocito T
- Linfoma
- Linfopoyesis
- Sangre
- Sistema inmunitario
Referencias
- ↑ a b Hatton, Chris S. R.; Hughes-Jones, Nevin C.; Hay, Deborah (2013). Hematología: Diagnóstico y tratamiento (9 edición). México DF, México: Editorial El Manual Moderno. ISBN 9786074483642. Consultado el 4 de julio de 2016.
- ↑ a b c Rodak, Bernadette F. (2005). «Parte II: Hematopoyesis». Hematología: fundamentos y aplicaciones clínicas (2 edición). Buenos Aires, Argentina: Ed. Médica Panamericana. pp. 134-142. ISBN 9789500618762. Consultado el 4 de julio de 2016.
- ↑ a b c d Actor, Jeffrey K. (2011). Elsevier Inc., ed. Elsevier’s integrated review immunology and microbiology [Revisión integrada de Elsevier: inmunología y microbiología] (en inglés) (2 edición). Pensilvania, Estados Unidos: Elsevier Health Sciences. ISBN 9780323074476. Consultado el 6 de julio de 2016.
- ↑ Palomo G., Iván; Pereira G., Jaime; Palma B., Julia, eds. (julio de 2009). «Capítulo 1: Hematopoyesis». Hematología: Fisiopatología y Diagnóstico. Talca, Chile: Editorial Universidad de Talca. pp. 43-66. ISBN 9789567059850. Archivado desde el original el 8 de agosto de 2016. Consultado el 4 de julio de 2016.
Enlaces externos
Wikcionario tiene definiciones y otra información sobre linfocito.
Wikimedia Commons alberga una categoría multimedia sobre Linfocito.
- Los Linfocitos y el Sistema Inmunológico (enlace roto disponible en Internet Archive; véase el historial, la primera versión y la última). tiene infografías y otra información sobre linfocito.

